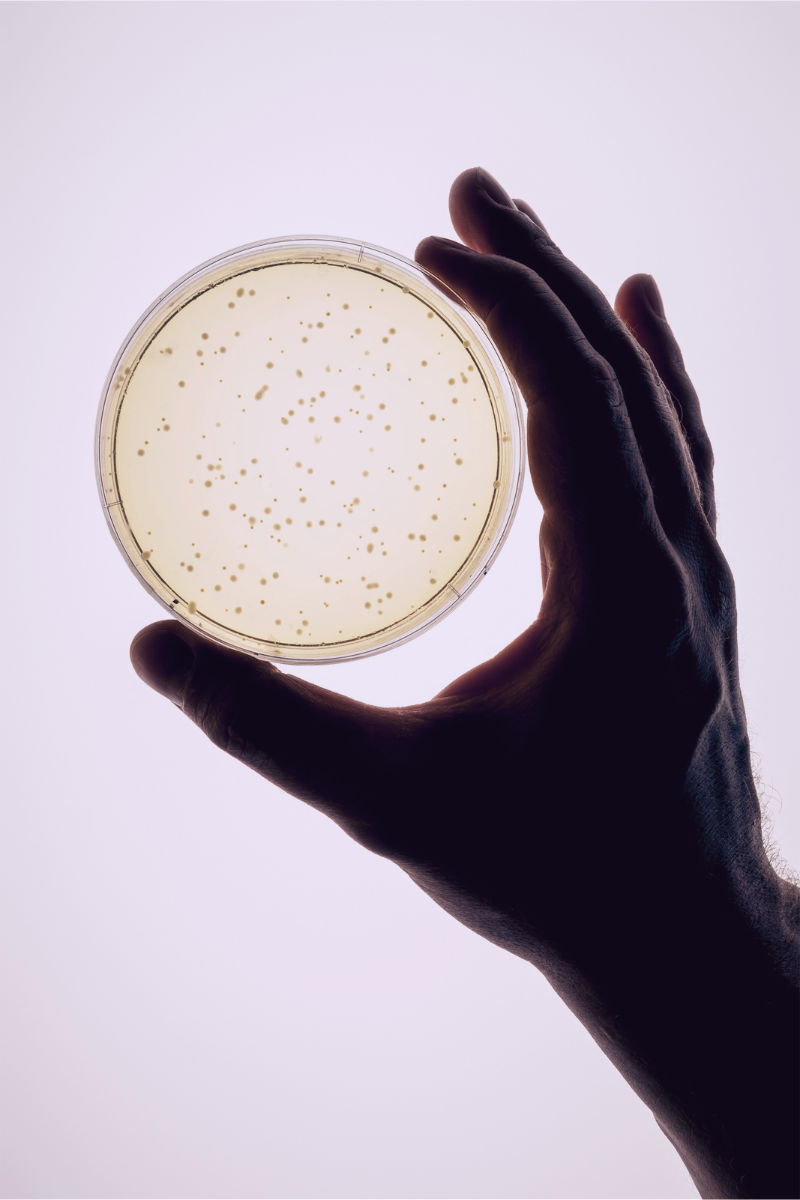

When choosing a probiotic, one of the most prominently displayed numbers on the label is the CFU count, or Colony Forming Units. This measure represents the number of live, viable bacteria in a dose of the probiotic, but many consumers mistakenly assume that more is always better. In reality, the effectiveness of a probiotic is not determined by the highest CFU count but by the specific strains used and the scientific research supporting their health benefits.
What Are CFUs and Why Do They Matter?
CFUs are used to quantify the number of live bacteria or yeasts in a probiotic product that can replicate and colonise in the gut. These microorganisms play a critical role in digestive health, immune function, and even mental well-being. However, the key to a probiotic’s success is not just the quantity of bacteria, but the strains included and their clinically studied benefits.
How CFU Counts Are Determined for Probiotic Efficacy
Each probiotic strain has unique properties and interacts with the gut in specific ways. The optimal CFU count for a given strain should be based on clinical research, not arbitrary high numbers. Scientific studies on probiotics typically determine the effective CFU range required for a particular health benefit.
Majority of Studies Support 1 to 10 Billion CFUs
Research indicates that most probiotic strains demonstrate benefits at doses between 1 and 10 billion CFUs per day. Some strains require slightly higher doses for specific health outcomes, but beyond a certain point, additional bacteria do not necessarily enhance effectiveness. This is why a well-researched probiotic will always list the strains included along with their studied CFU doses, ensuring you receive the right amount for meaningful health benefits.
Why a Higher CFU Count Isn’t Always Better
Many probiotic products emphasise extremely high CFU numbers, such as 50 or 100 billion, to appear more potent. However, this can be misleading for several reasons:
-
Not all bacteria are equally beneficial. Some bacterial strains are easy to grow at high concentrations and may be used to artificially increase CFU counts in a product. These strains may not be the most well-researched or the most effective for gut health, but they allow manufacturers to market a higher CFU count.
-
Some strains are more difficult and expensive to produce. High-quality, well-studied probiotic strains may be more difficult to ferment and manufacture at high CFU counts. This means a probiotic containing 5 billion CFUs of a clinically validated strain may be far superior to one containing 50 billion CFUs of generic or less-effective strains.
-
More bacteria do not always mean better colonisation. Taking extremely high CFU doses does not necessarily mean more bacteria will survive and thrive in your microbiome. Strain specificity and clinical research matter more than sheer quantity.
How to Choose an Effective Probiotic
When selecting a probiotic, focus on the quality and research behind the strains rather than the CFU count alone. Here are key factors to consider:
-
Look for Strain-Specific Research: Ensure the probiotic contains well-researched strains with published clinical studies supporting their benefits.
-
Check the CFU Dosage in Studies: The CFU count should align with the dosage used in successful human trials (often between 1 and 10 billion CFUs per strain).
-
Avoid High-CFU Gimmicks: Be cautious of products advertising excessively high CFU numbers without specifying the strains or their scientific backing.
-
Verify Stability and Viability: Probiotics should be formulated to survive manufacturing, storage, and passage through stomach acid so they reach the gut alive.
Why Trusted Sources Matter for Probiotic Information
With the growing popularity of probiotics, many companies prioritise marketing over science, making it essential to rely on sources that provide evidence-based information. Trustworthy probiotic brands and sources will always be transparent about strain selection, scientific validation, and appropriate CFU dosing.
At Goodbac, we focus on clinically validated strains at the optimal CFU count for effectiveness, never using high-CFU marketing tactics or unverified bacterial blends. Our approach ensures that you receive the right bacteria, at the right dose, based on real science.
By understanding CFUs and focusing on research-backed probiotics, you can make an informed decision that supports your gut health in the most effective way possible.